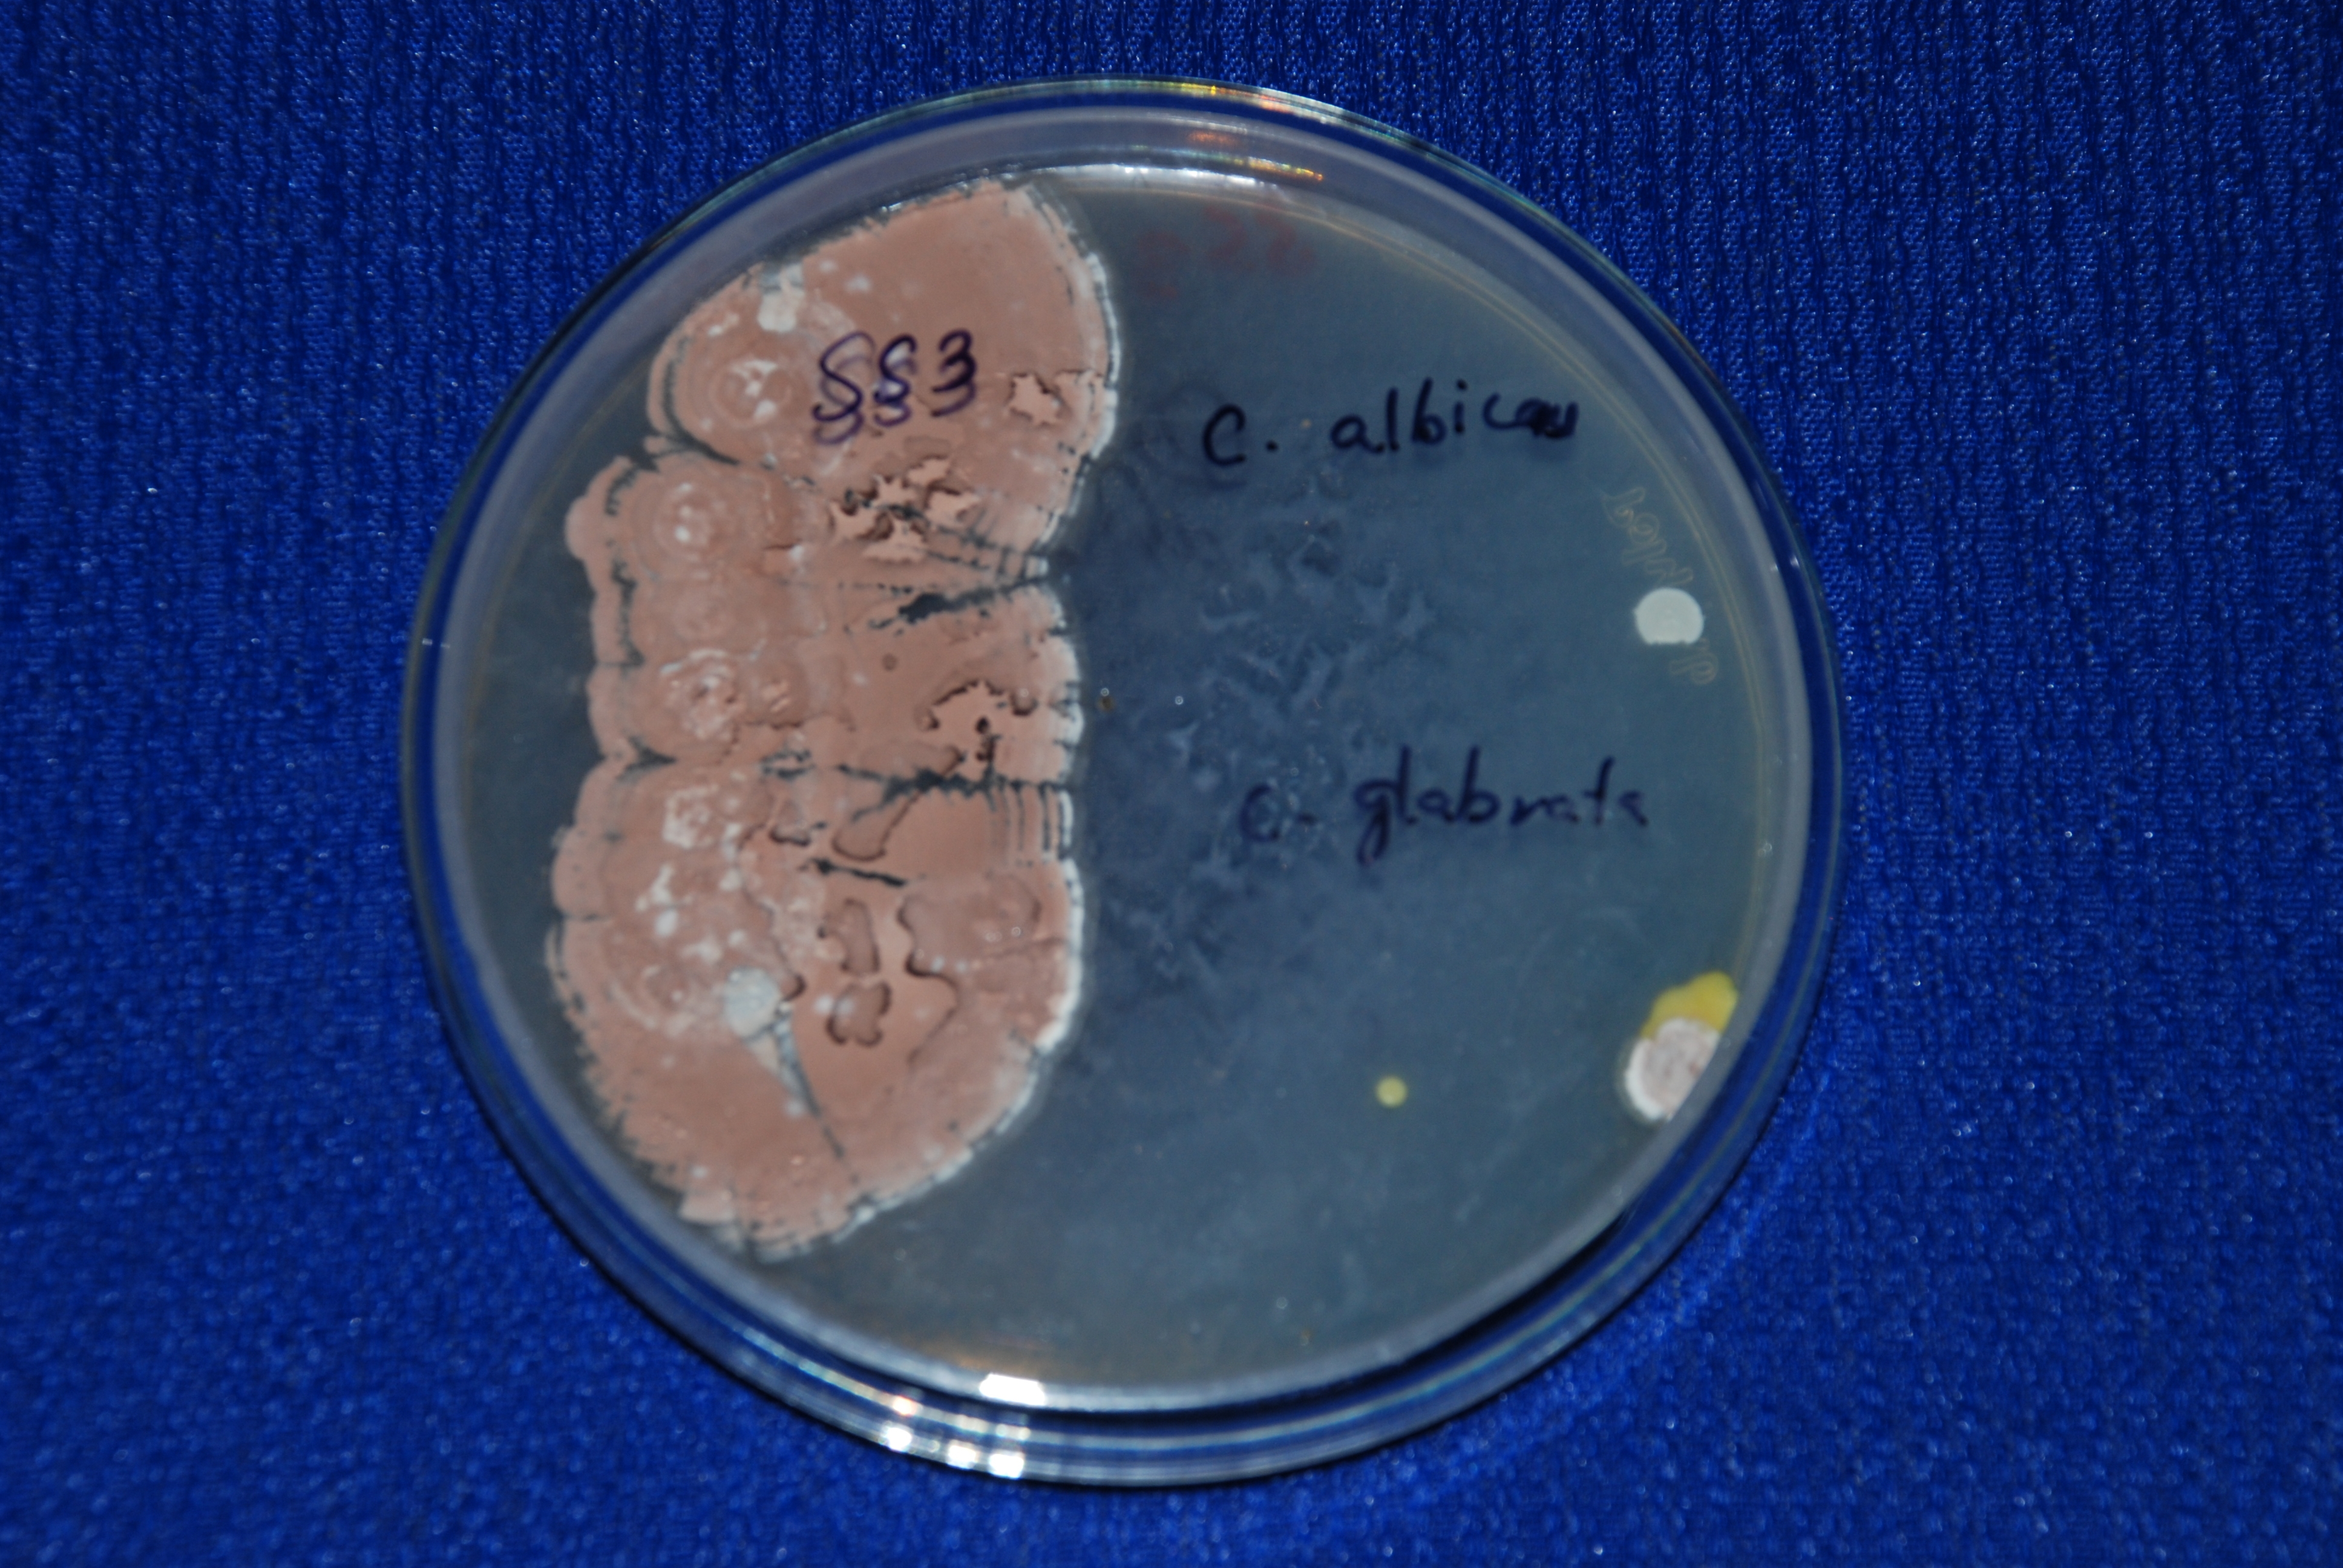

1Assistant Professor, Department of Biotechnology, Sathyabama University, Jeppiaar Nagar, Rajiv Gandhi Salai, Chennai 600119, Tamil Nadu, India, 2,3Department of Biotechnology, Sathyabama University, Jeppiaar Nagar, Rajiv Gandhi Salai, Chennai 600119, Tamil Nadu, India.
Email: missusha@yahoo.com
Received: 08 Oct 2014 Revised and Accepted: 10 Nov 2014
ABSTRACT
References and further reading may be available for this article. To view references and further reading you must purchase this article.
Objective: To identify antifungal compounds from marine Streptomyces.
Methods: Strptomyces were isolated from marine soil sample by the spread plate method. From the active strain crude compounds were extracted by the solvent extraction method. Crude compounds were purified by TLC method. Then the identification of compounds done by GC-MS analysis.
Results: One of the active strain was identified as Streptomyces rubralavendulae strain SU1 (HQ234765). The antifungal compounds were shown resistant to Candida albicans. The antifungal compounds were identified by GC-MS as 2-Isopropyl-5-methyl-1-heptanol and Eicosane.
Conclusion: These results could support the suggestion of Streptomyces as an alternative of the host for medicinal activity for treating fungal infections.
Keywords: Streptomyces, GC-MS, Antifungal compound, TLC, Marine soil.
INTRODUCTION
Streptomycetes are an important group of filamentous, Gram-positive bacteria producing antibiotics of agriculture and medicinal importance. Streptomyces species rank first and cover around 80% of total antibiotics [1]. Though there are the number of antibiotics the need to search for new and efficient antibiotic producing strains keeps rising due to the emergence of drug resistant pathogens [2]. Strains of the genus streptomyces are superior to other actinomycete strains in their ability to produce large numbers and varieties of bioactive metabolites [3]. Among the different types of drug prevailing in the market, antifungal antibiotics are very small but significant group of drugs and have an important role in the control of mycotic diseases.
The need for new, safe and more effective antifungal is a major challenge to the pharmaceutical industry today, especially with the increase in opportunistic infection in the immune compromised host [4]. Particularly the incidence of infections by opportunistic fungi are increasing especially in patients who immune systems are compromised by AIDS, cancer, diabetes, age and other causes. Many antifungal compounds have been identified not safe and effective antifungal drugs have not yet been developed because of the high degree of similarity between fungi and mammalian cells [5]. Therefore, Azole group antifungal agents, Myconazole, Ketoconazole, fluconazole and itraconazole are also used in clinically, but these medicines have nephrotoxicity and hepato toxicity and cause vomiting and importance [6]. This has consequently resulted in a strong demand for potent drugs that have least side effects and the search for the new antifungal metabolites remains as a challenging task.
In this present study, concentrate about the search for new antifungal metabolites led to the isolation and identification of streptomyces strains from marine soil sediments.
MATERIALS AND METHODS
Isolation and subculture of streptomyces
Ten marine soil sediments were collected from Tamil Nadu coastal areas. The soil samples were air dried for 2 days and kept at 45°C in hot air oven for 10 mins to prevent bacterial and fungal contamination. The soil samples were processed by the serial dilution method and spread plate method by using 50% seawater in starch – casein agar medium [7;8]. The isolated colonies were subcultured by ISP-2 medium.
Primary screening for antifungal activity
The primary screening of all the isolates were screened for their antifungal activity by cross streak method [9] by using modified nutrient agar against six pathogenic fungi. The results were noted based on the presence of full or half moon shaped fungal growth on the medium after 4 days of incubation.
Extraction and secondary screening of antifungal compounds
The identified only one active strain was processed for extraction of crude compounds by using ISP-2 medium by ethyl – acetate extraction method [10]. The active strain was inoculated in ISP-2 broth containing 50% sea water and incubated for 7 days in shaker incubator at 24°C. After incubation culture broth was centrifuged at 8,000 rpm for 15 mins and the supernatant was collected and mixed with an equal volume of ethyl acetate. The extracted crude compounds were dried at 40°C. The crude compounds were processed for secondary screening by agar well diffusion method [11] to confirm the active antifungal metabolites.
Purification of crude compounds - TLC
Purification and separation of crude compounds were processed by Thin Layer chromatography method [12]. The readymade pre coated TLC plates were used for separation of crude compounds. Using the capillary tube a row of spots of the active elutant was applied a line 1.5 cm above from the bottom of TLC plates. The spots were left to dry. The TLC plate was placed vertically in a trough containing the solvent (hexane - ethyl acetate) 1: 9). When the solvent moved up to 80% of TLC plate, the plate was taken out and dried. The Rf values were calculated. Then the plates were viewed under UV-light. Each bands were scrapped out separately and collected in different vials. Then the each band compounds were checked again for antifungal metabolites by agar well diffusion method.
Identification of antifungal compounds
The active band compounds were identified by using (Gas chromatography and mass spectromentry) GC-MS method. The mass spectrum was recorded by using SHIMADZU QP2010. Mass spectrometer under the current (MA) 100 and the temperature at 70°C.
Identification of active strain
One of the most active strains was subjected to identified based on cultural characteristics, microscopic spore morphology and 16S rRNA partial gene sequencing.
RESULTS AND DISSCUSSION
Isolation and subculture of Streptomyces
Forty isolates were isolated based on their different colony morphological colour variations. The varies colour colonies were purified by repeated streak on ISP-2 medium. Based on the growth 15 strains were further selected and tested for antifungal activity. In a similar study, 88 Actinomycetes were isolated from 26 marine sediments collected near nine Islands of Andaman coast of the Bay of Bengal [13] and eighty strains of actinomycetes were isolated from 20 marine sediments collected from Maharastra and Goa coast using eight specific media [14].
Primary screening for antifungal activity
The fifteen isolates were tested against six pathogenic fungi by using cross streak method. Out of all strains, third strain (SS3) more active against all the human and plant pathogenic fungi. SS3 strain showed more resistant to Candida albicans and Candida glabrata. Antifungal activity of SS3 showed in (fig. 1). Among the sixteen, isolates of streptomycetes isolated from marine sediments, six were exhibited antifungal activity by cross streak method [15].
Fig. 1: Antifungal activity of SS3 activity against Candida albicans and Candida glabrata
Extraction and secondary screening of antifungal compounds
The crude antifungal compounds were extracted from active strain by using ethyl acetate extraction method. The (10 µl) of crude compounds were checked for antifungal activity by the agar well diffusion method. In secondary screening method the active strain showed most active against Candida albicans. The percentage of zone of inhibition measured after incubation was shown in (fig. 2). Similarly [16] reported that the culture filtrate of active strains was inhibited in various pathogenic fungi. Out of 10 strains, only 4 strains namely Streptomyces griseoflavus (0.5 mm), Streptomyces cyaneus (0.1 mm), Streptomyces exfoliatus (0.3 mm) and Streptomyces albus (0.1 mm) showed the maximum level of inhibition zone towards the Aspergillus niger, whereas remaining species showed negative results.

Fig. 2: Antifungal activity of crude compounds from active strain
Identification of antifungal compound
The crude compounds were separated and purified by Thin layer chromatography. Three different bands were observed in Thin layer chromatography. All the bands were checked for antifungal activity by the agar well diffusion method. The Rf value of active band was 0.39. The zone of inhibition was checked for triplicate plates and results were showed and the active strain showed most active against Candida albicans (Table 1). The bioactive region of the separated compound was detected on the TLC plate at Rf 0.40 [17]. The GC-MS report of the active strain with active compound Eicosane (fig. 3) with the molecular weight of 282 dalton, molecular formula C20H42. retention time 17.958 and area percentage 0.44 %. The other active compound was reported as 2-Isopropyl-5-methyl-1-heptanol (fig. 4). Eicosane as a antifungal compound has been reported [18] and studied that the growth characteristics and production of secondary metabolites from selected novel streptomyces species isolated from kenyan national parks.
Table 1: Zone of inhibition of Streptomyces rubrolavendulae SS3 for the active band
| Fungal strains | Zone of inhibition in mm (50 µl) |
| Aspergillus niger | 10±0.3 |
| Aspergillus flavus | 12±0.1 |
| Candida albicans | 18±0.5 |
| Candida parapsillosis | 13±0.1 |
| Candida glabrata | 12±0.5 |
| Fusarium oxysporum | 11±0.5 |
| Trichoderma viride | 9±0.5 |
| Alternaria alternata | 7±0.5 |

Fig. 3: Mass Spectrum of the Eicosane

Fig. 4: Mass spectrum of the 2-Isopropyl-5-methyl-1-heptanol
Identification of active strain
The active strain SS3 was identified by cultural and microscopic characteristics. The active strain identified as Streptomyces rubralavendulae strain SU1 (HQ234765) by 16S rRNA partial gene sequencing. Results were showed in (Table 2).
Table 2: Cultural and Microscopic Characteristics of SS3 in SCA medium
| Characteristics | SS3 |
| Aerial mass colour | Pinkish white |
| Reverse side colour | Yellow |
| Reverse side pigment | - |
| Melanoid pigments | - |
| Soluble pigments | - |
| Spore chain morphology | Spirales |
| Spore surface morphology | Smooth |
| Growth | Good |
- Negtive, + positive
CONCLUSION
The ten marine soil sediments were collected from the Tamil Nadu coastal areas. Forty strains were isolated and fifteen active strains were selected from primary screening. Among the fifteen strains, only one active strain showed broad-spectrum activity against all the six pathogenic fungi. SS3 strain showed more resistant to Candida albicans. Purification of crude compounds were carried out by TLC and active band were confirmed by an agar well diffusion method. The pure compounds were identified as 2-Isopropyl-5-methyl-1-heptanol and Eicosane by GC-MS method. The most effective strain (SS3) was identified as Streptomyces rubralavendulae strain SU1 (HQ234765) based on morphological and 16S rRNA partial gene sequencing. From this study, suggested that Streptomyces isolated from the marine environment may be potentially used for extracting novel antibiotics for treating fungal infections.
CONFLICT OF INTERESTS
Declared None
ACKNOWLEDGEMENT
The authors are thankful to the Sathyabama University, Chennai for helping us to achieve good results.
REFERENCES